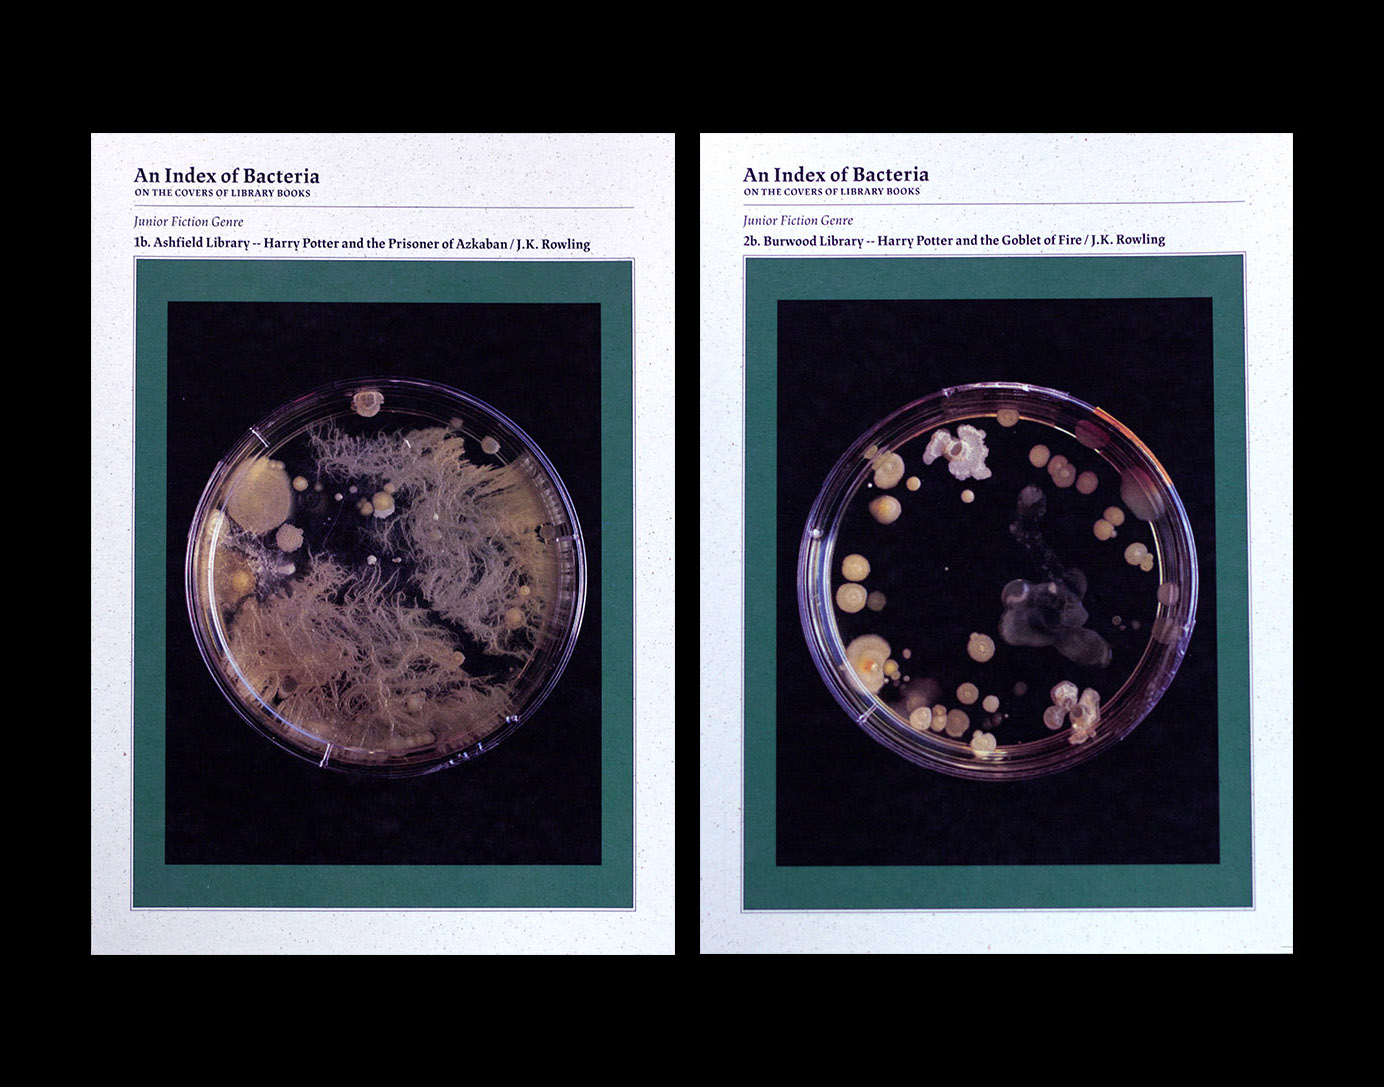

2017
An Index of Bacteria
An Index of Bacteria sought to investigate and reveal the invisible traces users have left on library books. As objects that are constantly passed from home to home, user to user and between different environments, library books undoubtedly accumulate remnants of these journeys on their surfaces.
An Index of Bacteria looked closely at popular library books from two different libraries in Sydney, and swabbed their covers for these traces. These swabs were then transferred to an agar dish to allow for bacteria to grow over the course of a couple of weeks. The resulting growths presented entire unseen worlds found living on the covers of these library books, and made visible the accumulated traces of use left from their travels.
This project is a continuation of the research began in What we left behind.